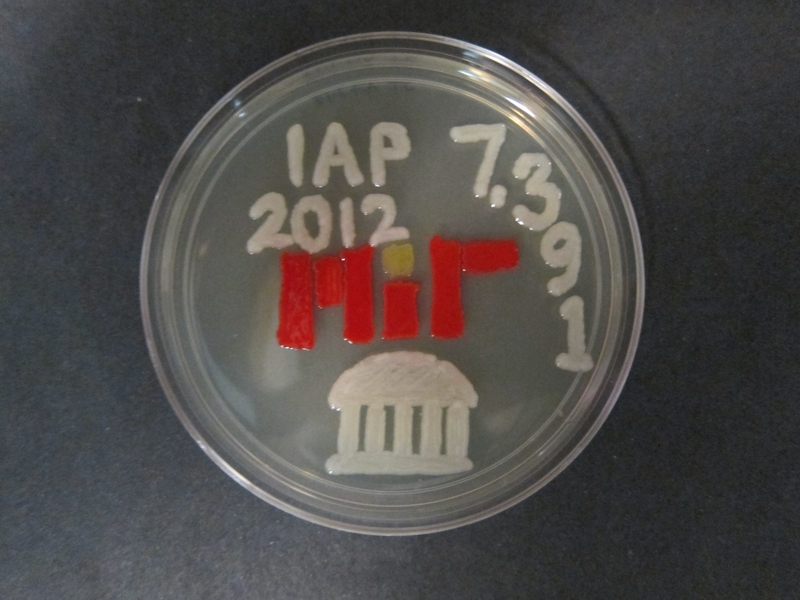
While waiting between experiments, Jennifer Thornton used some of the colorful bacteria to show her artistic side.

This Independent Activities Period (IAP), 12 freshmen were given the important task of finding a bacteriophage that specifically infects and kills a multi-drug-resistant bacterial strain — a bacterium that is also threatening the life of an 8-year-old boy. Welcome to IAP lab course 7.391 — “Introduction to Molecular Biology Techniques” — where the setting is imaginary, but the science is real.
What challenges did these freshmen face? They had exactly two weeks to isolate a bacteriophage — a virus that infects bacteria — and its host bacterium; purify and characterize the phage; and identify its host. These freshmen had never worked in a lab before, did not know how to use a pipette, and had none of the technical skills required for such an important time-sensitive mission. But this is MIT, where problem-solving and resourcefulness are the order of the day.
The students used standard lab techniques such as growing bacteria, performing polymerase chain reactions (PCR), and preparing DNA and protein gels. They also used advanced techniques such as ultracentrifugation and electron microscopy to accomplish their mission. The pace was fast and the work intense: Students needed to quickly learn how to master lab techniques, multitask, plan ahead and become independent.
“I like how the class is completely hands-on and throws you into the task immediately,” freshman Jaaron Botello said.
Since the students worked with uncharacterized strains of bacteria and phages, there was also a lot of troubleshooting. Experiments do not always work, which sometimes meant coming in to the lab as early as 8 a.m. and staying as late as 8 p.m., coming in on weekends, and on holidays during the January session. The course gave the first-year students some insights into life in the lab:
- “My experiments failed four times!” said freshman Pooja Jethani, whose bacterial strain was particularly uncooperative.
- “I learned that research is very time-consuming and that I should not stress out when an experiment does not work,” freshman Sophia Li said.
- “You have to think about what you are doing, not just read instructions,” Edgardo Farrias said.
- “The pace is really fast and you need to think on your feet. If the experiment failed we had to think about why it failed and what we had to do differently,” freshman Jonathan Calderon said.
- "I quickly learned how important it is to take note and to be really organized," freshman Jennifer Thornton said.
Course co-instructors Mandana Sassanfar, a Department of Biology instructor; and Brenda Minesinger, a biology research scientist, believe that the format of 7.391 is perfect, with its small class size. There is time to interact with each student and help to determine if he or she is understanding the concepts of the lab course. This allows the two instructors to cater to individual learning styles.
At the end of the course, the ficticuous little boy was saved and 12 freshmen were ready to apply for the Undergraduate Research Opportunities Program — knowing what to expect in a research lab setting, having just experienced firsthand the long hours, the ups and downs, and the frustrations and excitement that come with research.